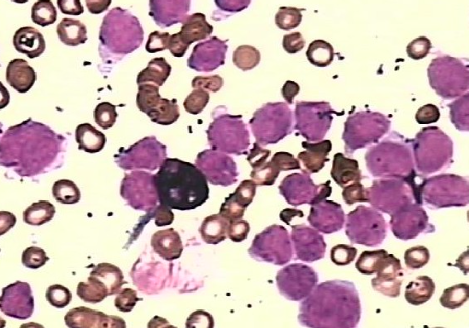
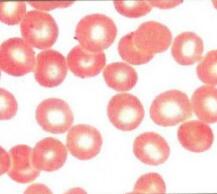

Q
问题编号: 28347
关于靶形红细胞叙述错误的是
A.直径可比正常红细胞大
B.厚度可比正常红细胞薄
C.细胞中心部位深染,边缘浅染
D.可能因HbA含量低而又分布不均所致
E.中央深染呈细胞边缘延伸的半岛状或柄状
问1:E中心深染也是错的啊应该是浅染吧
Q
问题编号: 45363
患者女32岁。近半年自觉发胖,乏力,易感冒。现水肿来就诊,空腹血生化TP52g/L,ALB22g/L,CHOL12.1mmol/L,LDL-C9.3mmol/L,BUN6.2mmol/L,Cr102.7mmol/L,Glu4.2mmol/L,尿蛋白5.5g/24h,尿蛋白(+++),尿白细胞(+),尿糖(-)。血常规Hb80g/L,其余正常。患者最可能的诊断是()
A.肾功能衰竭
B.急性肾小球肾炎
C.泌尿系统感染
D.糖尿病肾病
E.肾病综合症
问1:不理解为什么是肾病综合症?
Q
问题编号: 29998
阴道分泌物的检查不包括
A.阴道清洁度检查
B.寄生虫检查
C.真菌检查
D.pH值检查
E.虫卵检查
问1:E和B的区别是什么啊
Q
问题编号: 42301
医疗卫生资源分配最基本的伦理原则是
A. 公平
B. 公正
C. 公用
D. 效用
E. 效益
问1:答案是公平为什么选B
Q
问题编号: 45640
在内源性和外源性凝血途径中共同起作用的凝血因子是
A.因子VII
B.因子V
C.因子VIII
D.因子X
E.以上均不正确
问1:V因子不属于共同途径吗
Q
问题编号: 42280
正常人空腹12小时后,血清中不含有
A. HDL
B. LDL
C. IDL
D. VLDL
E. CM
问1:什么答案
Q
问题编号: 45627
尿肌红蛋白主要的检测方法有
A.单克隆抗体法、放射免疫法、酶联免疫吸附法
B.Pandy试验法、隐血试验法、酶联免疫吸附法
C.80%硫酸铵法、单克隆抗体法、酶联免疫吸附法
D.80%硫酸铵法、单克隆抗体法、放射免疫法
E.80%硫酸铵法、单克隆抗体法、隐血试验法
问1:隐血试验最主要是检测血红蛋白吗,怎么不选D嘞
Q
问题编号: 43971
骨髓涂片POX染色结果如图3 所示,该病例最可能是
A.ALL
B.APL
C.AML-M2a
D.AML-M4a
E.AML-M5b
问1:为什么
Q
问题编号: 41640
患者男,38岁。患肺结核后肺部形成空洞,超敏反应类型为
A.I型超敏反应
B.II型超敏反应
C.III型超敏反应
D.IV型超敏反应
E.速发型超敏反应
问1:为什么是四型?
Q
问题编号: 45622
胎儿羊水血型检查试验显示,抗A血清孔无凝集,抗B血清孔和抗H血清孔凝集,提示胎儿血型可能是
A.A型
B.B型
C.O型
D.AB型
E.非分泌型
问1:这题没懂,能详细解释下吗?这里题干不是B孔凝集吗,那B孔阳性,怎么不是B型呢
Q
问题编号: 32075
男性,5岁,自幼外伤后出血难止,患者发育正常,见皮肤瘀斑,测得出血时间(出血时间测定器法)10min,凝血酶原时间12.3s,活化部分凝血活酶时间62.1s,用硫酸钡吸附血浆可纠正,而正常人血清不能纠正。据此应诊断为
A.血小板无力症
B.血友病甲
C.血友病乙
D.血管性血友病
E.遗传性因子Ⅻ缺乏症
问1:想问下10大于10吗
Q
问题编号: 32064
下列哪组纠正试验可以诊断血友病
A.正常血清能纠正,硫酸钡吸附血浆不能纠正
B.正常血清和正常新鲜血浆都能纠正
C.正常新鲜血浆能纠正
D.硫酸钡吸附血浆能纠正,正常血清不能纠正
E.正常血清和硫酸钡吸附血桨都能纠正
问1:也是对的,被确诊血友病b
Q
问题编号: 38106
患者女,患Graves病。出现甲状腺功能亢进,属于
A.I型变态反应
B.II型变态反应
C.III型变态反应
D.IV型变态反应
E.应激反应
问1:1到4型各自常见变态反应
Q
问题编号: 38080
蛔虫性哮喘的免疫学反应属于
A.I型变态反应
B.II型变态反应
C.III型变态反应
D.IV型变态反应
E.迟发型变态反应
问1:1到4型常见的疾病免疫反应?
Q
问题编号: 44021
诊断心肌损伤特异性最高的酶是
A.Mb
B.CK-MB
C.cTn
D.LDH
E.BNP
问1:老师为什么不选c?
Q
问题编号: 41602
患者男,40岁。反复咳嗽、咳痰、低热1年,多次X线胸片及肺部CT显示右肺下叶炎症。病理活检组织,过碘酸-雪夫(PAS)染色,见大量分枝菌丝,末端呈球形膨大。下列有助于病原菌的鉴定的试验是
A.墨汁染色镜检
B.吉姆萨染色镜检
C.10%KOH湿片镜检
D.抗酸染色镜检
E.革兰染色镜检
问1:老师,这题有的答案是C,也有选E的。
Q
问题编号: 45612
用双位点一步法检测抗原时,若怀疑显示降低是由于钩状效应所造成,应采取何种措施
A.增加酶标抗体的用量
B.增加洗涤次数
C.延长反应时间
D.稀释抗原
E.稀释抗体
问1:钩状效应不是只能说抗原抗体比例不合适吗?前带是抗体过量,后带是抗原过量。这题怎么直接选了嘞
问2:因为它是检测抗原,结果降低所以就怀疑是抗原过量,需要稀释抗原。应该是这样理解吧
Q
问题编号: 41541
某患者的红细胞3.2X1012/L,HB88g/L,MCV78fl,MCH27.4pg,MCHC347g/L。该患者贫血的类型
A.小细胞低色素性贫血
B.大细胞性贫血
C.正细胞正色素性贫血
D.大细胞高色素性贫血
E.单纯小细胞性贫血
问1:与小细胞低色素性贫血有何区别?
Q
问题编号: 42319
可作为反映溃疡性结肠炎活动性最可靠的指标之一的物质是
A.前白蛋白
B.白蛋白
C.a1-酸性糖蛋白
D.β2-微球蛋白
E.CRP
问1:老师为什么不选crp?
Q
问题编号: 40682
[患者女,38岁,因关节肿痛半年就医,化验检查:抗核抗体(ANA)检验结果为1:40斑点型,类风湿因子(RF)检测结果为220IU/ml(参考范围<20IU/ml)]
关于ANA与RF的说法,正确的是
A.RF与ANA检测结果有相关性
B.ANA只见于SLE
C.RF与ANA检测结果无相关性
D.RF与ANA均为抗变性IgG的自身抗体
E.RF检测是确诊性实验
问1:有的答案给的有相关性
Q
问题编号: 37474
莱姆病的主要传播媒介
A.硬蜱
B.软蜱
C.体虱
D.接触疫水
E.性传播
问1:伯氏螺旋体是传播途径是什么,下面的解释不太一致
Q
问题编号: 41489
某地夏季突然出现腹泻病人群,发病人数在数日内迅速上升,但临床症状不典型,细菌学诊断中对病原菌的检验方法不推荐
A.分离培养
B.直接涂片镜检
C.血清学试验
D.动物试验
E.人体试验
问1:为什么不推荐人体试验?
Q
问题编号: 41419
体内糖代谢最主要的途径是
A.糖酵解途径
B.糖有氧氧化途径
C.糖原合成途径
D.糖异生
E.磷酸戊糖途径
问1:为什么不选b?
Q
问题编号: 31809
血清中主要含有的凝血因子是
A.因子VII、X
B.因子V、VIII
C.因子II、V、VII、X
D.因子I、III、V、VII
E.因子I、XIII
问1:血清不含的应该是1258呀
Q
问题编号: 41380
属于II性超敏反应疾病的是
A.血清病
B.接触性皮炎
C.新生儿溶血
D.类风湿关节炎
E.荨麻疹
问1:血清病属于几型?
Q
问题编号: 31697
下列哪一项不符合类白血病反应的骨髓象特点
A.粒细胞常有毒性改变
B.可见粒细胞核左移
C.骨髓象往往有明显的变化
D.红系和巨系无明显异常
E.原始和幼稚细胞增多
问1:17题又远E
Q
问题编号: 31690
类白血病患者的骨髓象显示为
A.增生极度活跃
B.增生明显活跃
C.增生活跃
D.增生明显减低
E.增生极度减低
问1:17题又说明显活跃没错
Q
问题编号: 46382
患者,女,58岁。右乳无痛性肿块入院。查体:右乳蚕豆大小包块,表面粗糙,活动地度差,皮肤有橘皮样改变。初步诊断为乳腺癌。
下列选项中,对乳腺癌有较好特异性的是
A. AFP
B. CEA
C. CA153
D. CA125
E. CA199
问1:老师,这几个都对应哪些疾病呢?
Q
问题编号: 44299
遗传性球形红细胞增多症的血常规结果可出现
A.MCV增大,RDW正常
B.MCV增大,RDW增大
C.MCV增大,RDW减小
D.MCV减小,RDW正常
E.MCV正常,RDW增大
问1:不是属于正细胞均一性贫血类型吗??
正细胞均一性常见疾病:再生障碍性贫血、遗传性球形红细胞增多症,急性失血、白血病。
小细胞均一性贫血常见疾病:轻型珠蛋白生成障碍性贫血,某些继发性贫血。
Q
问题编号: 34191
抗原性是指
A.能与免疫应答产物发生特异性反应的特性
B.免疫原性
C.能诱导免疫应答的特性
D.能刺激机体免疫系统产生抗体与致敏淋巴细胞的特性
E.抗原与载体结合后诱导免疫应答的特性
问1:这个不应该选c吗,a是反应性吧
Q
问题编号: 42242
患者,男,45岁。突然感觉胸痛,4小时后到医院就诊,心电图ST段抬高,以下哪项检查对于排除急性心肌梗死的首要指标
A. CK
B. CK-MB亚型
C. cTn
D. Mb
E. LDH
问1:哪有DM
Q
问题编号: 41714
远端肾小管中毒
A.尿HCO3-↑
B.尿HCO3-↓
C.高钾
D.低钾
E.高血氯
问1:答案写的远端肾小管中毒,有高氯,低钾,为什么答案是高氯,低钾是错的?
Q
问题编号: 41278
不属于A群链球菌致热外毒素的致病特点的是
A.致热作用
B.细胞毒作用
C.增加宿主对内毒素的敏感性
D.抗原性弱
E.产生皮肤红疹
问1:选项不全面
Q
问题编号: 42149
患者,男,58岁。查体心肺(-),X线检查未见异常。实验室检查:血清K3.6mmol/L,Na142mmol/L,Ca2.95mmol/L,P1.05mmol/L,BUN6.5mmol/L,Alb45g/L,ALP72U/L。该患者检查结果表现为高钙血症,下一步应做的检查是
A. 血清PTH
B. 血FT3、FT4
C. 血17-羟皮质类固醇
D. 血NE
E. 血5-HT
问1:该题笔记
Q
问题编号: 28338
血涂片镜检如图2所示,剪头所指的是
A.红细胞裂片
B.口形红细胞
C.球形红细胞
D.靶形红细胞
E.低色素红细胞
问1:箭头在哪
Q
问题编号: 43835
关于血糖测定标本保存的叙述,错误的是
A.采血后应在1小时内分离血清或血浆
B.血清应及时做血糖测定
C.氟化物的氯离子抑制烯醇化酶而抑制糖酵解
D.全血在室温下放置,血糖浓度每小时可下降2%~3%
E.如用血浆测定,采用肝素抗凝最好
问1:E错的不是更明显吗?
Q
问题编号: 43832
诊断神经梅毒的首选试验是脑脊液的
A.压力测定
B.蛋白定量
C.免疫球蛋白测定
D.密螺旋体荧光抗体吸收试验
E.玻片试验(VDRL)
问1:为什么不选e?
Q
问题编号: 30466
患者女,36岁,因贫血、月经过多入院。骨髓涂片形态学检查结果显示:呈急性白血病骨髓象,91%的白血病细胞,胞体中等大小,核型较不规则,核仁模糊,胞浆量较多,含大量细小的紫红色颗粒,Auer小体易见。对此患者进行分型,最有意义的细胞化学染色是
A.铁染色
B.过氧化物酶染色
C.糖原染色
D.特异性酯酶染色
E.苏丹黑染色
问1:为什么不是选B?
Q
问题编号: 35837
患者,女性,35岁,因乳房肿块就诊。査体;右侧乳房外上象限可触及一卵圆形均实性肿块,质较硬。患者术后肿瘤标志物水平明显降低,建议1年内的监测频率为
A.每周1次
B.每月2次
C.每月1次
D.每2个月1次
E.每半年1次
问1:到底选啥
Q
问题编号: 43458
关于结核分枝杆菌生物学特征叙述,正确的是
A.属于厌氧菌
B.革兰染色为阴性菌
C.对酸碱环境敏感
D.致病因子为内毒素
E.菌落为粗糙菜花样
问1:结核杆菌的特征
Q
问题编号: 42419
瑞氏染液的质量规格可以用吸光度比值(rA)来评价。以下哪个rA的数值,染色效果最好
A.1.1
B.1.3
C.1.6
D.1.8
E.2.1
问1:D不是1.8吗
Q
问题编号: 30984
患者女,25岁。15岁时开始出现乏力、头晕、月经量过多。曾用铁剂治疗,症状无明显改善。体检:皮肤黏膜苍白,贫血貌,余无异常。外周血检查:Hb82g/L,RBC3.5×10e12/L,HCT0.29,RDW15.5%。最可能的诊断是
A.珠蛋白生成障碍性贫血
B.再生障碍性贫血
C.缺铁性贫血
D.急性失血性贫血
E.慢性感染性贫血
问1:老师这个题我有点小疑惑。
Q
问题编号: 43436
反向间接凝集试验阳性时可出现
A.红细胞溶解
B.红细胞凝集
C.红细胞不溶解
D.红细胞不凝集
E.红细胞沉淀
问1:凝集反应
Q
问题编号: 41961
【病例:乳酸脱氢酶(LDH)是一种糖酵解酶,主要作用是催化乳酸氧化为丙酮酸,将氢转移给NAD成为NADH。】
[这里到时候配个图]
第二问:如上图曲线显示,加入试剂R2的时间是
A.10
B.16-20
C.15
D.17
E.21
问1:图丢了?
Q
问题编号: 32164
体内糖代谢最主要的途径
A.糖酵解
B.糖有氧氧化
C.糖异生
D.磷酸戊糖途径
E.糖醛酸途径
问1:糖的有氧氧化不是糖代谢的主要途径吗
Q
问题编号: 45419
外周血T细胞及其亚类的计数中,CD4/CD8比值预示急性排斥反应即将发生的是
A.<0.5
B.<1.0
C.1.4~2.0
D.>1.2
E.<1.4
问1:CD4/CD8比值正常范围1.4/2.0。急性排斥反应不是CD8会升高,比值下降吗,怎么答案会是大于1.2呢
Q
问题编号: 35173
下列各种自身抗体对诊断SLE的特异性最高的是
A.抗Sm抗体
B.抗ds-DNA抗体
C.ANA
D.抗u1RNP抗体
E.抗Scl-70抗体
问1:不是应该选b吗
问2:特征性与特异性到底有啥区别
Q
问题编号: 40816
关于骨髓涂片的检查,不正确的是
A.应综合细胞大小、核质比例、核的形状、染色质结构、核仁、胞质着色和颗粒等条件全面分析判断
B.原始细胞虽各有特征,但极相似,甚难鉴别,除应做相应的细胞化学染色协助区别,也可根据伴随出现的幼稚细胞或成熟细胞,推测原始细胞的归属
C.介于两个阶段之间的细胞,不论其来源如何,应统一按成熟方向的下一阶段计算
D.介于浆细胞和幼红细胞之间的细胞,可归于浆细胞
E.实在难以确定类型的细胞,可列为“分类不明细胞”
问1:此题,两个E选项、记得修改过来哦
Q
问题编号: 38008
培养基的质量控制不包括
A.配制好的培养基随机抽取5%~10%的量做无菌试验
B.MH平板的厚度应为4mm,其他平板厚度一般为3mm
C.配制好的培养基pH应与规定的pH相差±0.2以内
D.一般平板培养基2~8℃可贮存1~2周,兔血平板至多保存一周
E.均应用已知性质的标准菌株进行预测,合格者方可使用
问1:不是选e吗,怎么答案是a
Q
问题编号: 41021
测定HCG敏感度最高的试验是
A.单克隆胶体金法
B.乳胶凝集抑制试验
C.放射免疫法
D.生物化学法
E.免疫比浊法
问1:答案好像错了
Q
问题编号: 46146
关于乳糜尿的说法错误的是
A. 严重的乳糜尿静置后分为4层外观呈不同程度的乳白色、白色中混有粉红色、白色中混有
B. 胶胨样
C. 可以诊断丝虫病
D. 有淋巴液
E. 乳糜尿排出体外易形成白色透明胶状凝块
问1:那 c 选项可以诊断丝虫病呢
Q
问题编号: 40753
临床上判断上消化道出血停止最可靠的指标是
A.粪镜检无红细胞
B.无柏油样黑便
C.粪隐血试验阴性
D.粪胆素试验阴性
E.粪胆原试验阴性
问1:柏油样黑便见于那些?
Q
问题编号: 33687
符合垂体腺瘤性甲亢的试验结果是
A.T3T4↑、TSH↓、TRH兴奋试验(-)
B.T3T4↓、TSH↓、TRH兴奋试验(-)
C.T3T4↑、TSH↑、TRH兴奋试验(-)
D.T3T4↑、TSH↑、TRH兴奋试验(+)
E.T3T4↓、TSH↑、TRH兴奋试验(+)
问1:垂体腺瘤性甲亢TRH试验有的资料上是阴性
Q
问题编号: 37834
对于血培养瓶,如无细菌生长痕迹,应在几天后发出报告
A.7天
B.5天
C.8天
D.9天
E.6天
问1:不应该是五天吗怎么会是7天呢
Q
问题编号: 40759
外周血涂片镜检如图4所示,剪头所指的细胞是
A.椭圆形红细胞
B.正常红细胞
C.靶形红细胞
D.巨大血小板
E.镰性红细胞
问1:没看到剪头
Q
问题编号: 30690
某患者MCH为20pg,MCV为80fl,MCHC为250g/L,可能诊断为
A.巨幼细胞性贫血
B.正常细胞性贫血
C.单纯小细胞性贫血
D.小细胞低色素性贫血
E.缺铁性贫血
问1:题目错的
Q
问题编号: 40850
下列疾病与其相应检查搭配正确的是
A.血红蛋白病一红细胞脆性试验
B.PK缺陷症-高铁血红蛋白还原试验
C.冷凝集综合征-血红蛋白电泳
D.免疫性溶血性贫血一抗人球蛋白试验
E.阵发性睡眠性血红蛋白尿症一一血红蛋白A测定
问1:错题对应正确的检查搭配答案
Q
问题编号: 42316
混合性结缔组织病(MCTD)的标志抗体是
A. 抗Sm抗体
B. 抗Sc1-70抗体
C. 抗SSB抗体
D. 抗Jo-I抗体
E. 高滴度抗RNP抗体
问1:重点科普
Q
问题编号: 42295
患者,女,23岁。低热、头痛乏力、腹痛,水样便。食用过海鲜、生鱼片等食物。送检样本镜检可见大量运动活跃的弧状杆菌。合适的分离培养基是
A. 血琼脂培养基
B. EMB培养基
C. SS培养基
D. TCBS培养基
E. Skirrow培养基
问1:Tcbs是?
Q
问题编号: 42291
下列可引起PT延长的是
A. 缺乏FVIII
B. 缺乏FIX
C. 缺乏FXII
D. 缺乏FXI
E. 缺乏FVII
问1:所有凝血指标的缩短与延长的临床意义?
Q
问题编号: 42287
血沉增快见于
A. 良性肿瘤
B. 红细胞增多
C. 恶性肿瘤
D. 白蛋白增多
E. 弥散性血管内凝血
问1:血沉降低呢?
Q
问题编号: 42280
正常人空腹12小时后,血清中不含有
A. HDL
B. LDL
C. IDL
D. VLDL
E. CM
问1:改题的答案是?
问2:改题的答案是?
Q
问题编号: 42269
患者血涂片检查,若镜下白细胞为5个/HP,可初步判断其外周血中白细胞总数大约为
A. 5×10^9/L
B. 6×10^9/L
C. 9×10^9/L
D. 10×10^9/L
E. 11×10^9/L
问1:请问白细胞分类是?红细胞的分类是?血小板有分类吗?
问2:为什么?
Q
问题编号: 42304
唯一一项可以同时反映肝脏合成功能、分泌功能和代谢功能三方面的血清学非酶学生化指标
A. DBIL
B. CHE
C. TBA
D. PA
E. TBIL
问1:Che是什么?
Q
问题编号: 42307
患者近一个月来消瘦、多饮、多食、多尿,检测空腹血糖为11.1mmol/L。可能的诊断是
A. 糖耐量受损
B. 新发的糖尿病
C. 空腹血糖受损
D. 糖尿病未控制
E. 无糖尿病
问1:什么是新发型糖尿病?
Q
问题编号: 42318
系统性红斑狼疮(SLE)的标志性抗体是
A. 抗Sm抗体
B. 抗Sc1-70抗体
C. 抗SSB抗体
D. 抗Jo-I抗体
E. 高滴度抗RNP抗体
问1:抗sm是什么?
Q
问题编号: 32076
女性,45岁,确诊胃癌后行冒大部切除术。手术止血完善,次日出现血腹。检验:血小板、BT、CT正常,阿司匹林耐量试验延长3min,APTT58s(正常对照36s),血小板粘附功能降低,因子Ⅷ:Ag活性为1%,血小板对瑞斯托霉素无聚集反应。最可能的诊断是
A.血友病A
B.血友病B
C.因子Ⅺ缺乏症
D.血小板无力症
E.血管性血友病
问1:BT正常,非延长
Q
问题编号: 42235
患者,男,48岁。因双膝关节红、肿胀、疼痛而就诊。发病前2周有上呼吸道感染病史。实验室检查:ASO(+),RF(-),抗CCP抗体(-),AKA(-)。最可能诊断是
A. 风湿性关节炎
B. 类风湿性关节炎
C. 腱鞘炎
D. 感染性关节炎
E. 骨关节炎
问1:Ccp是啥
Q
问题编号: 42323
鉴别慢性粒细胞性白血病与类白血病反应,首选试验是
A. PAS染色
B. POX染色
C. 铁染色
D. NAP染色
E. 氯乙酸AS-D萘酚酯酶染色
问1:Pas 是什么
Q
问题编号: 32285
以下有可能是健康成人的OGTT检测结果的是
A.空腹血糖6-7mmol/L
B.口服葡萄糖60-90分钟达最高峰
C.葡萄糖峰值〉11.1mmol/L
D.2小时血糖水平在7-8mmol/L
E.血糖峰值<11.1mmol/L
问1:2h 7-8不对吗
Q
问题编号: 42280
正常人空腹12小时后,血清中不含有
A. HDL
B. LDL
C. IDL
D. VLDL
E. CM
问1:选项M是什么
Q
问题编号: 42242
患者,男,45岁。突然感觉胸痛,4小时后到医院就诊,心电图ST段抬高,以下哪项检查对于排除急性心肌梗死的首要指标
A. CK
B. CK-MB亚型
C. cTn
D. Mb
E. LDH
问1:参考答案D,M是什么意思啊,没有M选项啊
Q
问题编号: 37395
下列关于肺炎支原体培养特性描述不正确的是
A.主要以二分裂繁殖
B.生长需要胆固醇和葡萄糖
C.菌落能吸附豚鼠红细胞
D.能产生溶血素
E.平皿上初代菌落呈“荷包蛋”状
问1:为什么选e??
Q
问题编号: 46364
患者,男,24岁。因发热、头痛、呕吐1周入院。查体:T38.4℃,颈项强直。脑脊液细胞计数,有核细胞数为415×10^6/L,主要为淋巴细胞。
患者的诊断初步考虑为
A. 化脓性脑膜炎
B. 蛛网膜下腔出血
C. 结核性脑膜炎
D. 新型隐球菌性脑膜炎
E. 病毒性脑膜炎
问1:为什么选结核性
Q
问题编号: 40543
染色实验用于检查
A.肝吸虫
B.肺吸虫
C.疟原虫
D.弓形虫
E.血吸虫
问1:疟原虫,不也是染色法吗
Q
问题编号: 35967
革兰阳性菌重要的细胞壁成分是
A.外膜
B.脂多糖
C.磷壁酸
D.脂蛋白
E.肽聚糖
问1:这个题目为什么不能选择肽聚糖,G+菌最多的是肽聚糖。磷酸璧是其特殊成分。
Q
问题编号: 28675
血型反定型时,标准红细胞与受检者血清均不发生凝集,则受检者血型为
A.A型
B.B型
C.AB型
D.0型
E.A1亚型
问1:这题我看不懂,不是反定型吗?没有AB抗体
Q
问题编号: 28654
孕妇,36岁,血型O型,第一胎男孩,A型血,健康,第二胎什么血型容易发生新生儿溶血
A.A
B.B
C.O
D.抗D抗体
E.AB
问1:老师,这个我理不清思路
Q
问题编号: 40735
如图1所示,图中有核细胞是
A.中性粒细胞
B.中性晚幼粒细胞
C.中性中幼粒细胞
D.淋巴细胞
E.单核细胞
问1:题目图片看不见
Q
问题编号: 29677
正常脑脊液蛋白质电泳图谱中显示含量最多的球蛋白为
A.α1-球蛋白
B.α2-球蛋白
C.β-球蛋白
D.γ-球蛋白
E.白蛋白
问1:含量最多不应该是清蛋白吗?
Q
问题编号: 40540
外周血涂片镜检如图3所示,箭头所示细胞是

A.淋巴细胞
B.单核细胞
C.中性粒细胞
D.嗜酸性粒细胞
E.嗜碱性粒细胞
问1:这个不是是嗜酸性粒细胞吗 答案怎么成了嗜碱性粒细胞了。
Q
问题编号: 35672
巨球蛋白血症时,可发生
A.高黏滞血症
B.免疫球蛋白异常增高
C.溶骨性病变
D.本周蛋白
E.T细胞功能异常
问1:为什么不能选择B,巨球蛋白血症的时候,免疫球蛋白不升高吗?
Q
问题编号: 33969
免疫防御过低
A.超敏反应
B.免疫缺陷病
C.自身免疫病
D.恶性肿瘤
E.感染
问1:为什么不选感染?
Q
问题编号: 29492
关于粪便中微生物的叙述,错误的是
A.成人粪便中细菌以大肠埃希菌、厌氧杆菌和肠球菌为主
B.健康婴幼儿粪便中可有酵母菌
C.粪便中细菌较多,约占干重的一半以上
D.婴幼儿粪便中细菌主要为双歧杆菌、拟杆菌、葡萄球菌等
E.粪便革兰阴性杆菌严重减低,球菌或真菌明显增多时,可出现假膜性肠炎
问1:选项C的解析是否有误?细菌干重占比应为1/3
Q
问题编号: 37885
[患者女性,45岁。3天前突发高热,寒战,腰痛,并有尿频、尿急及排尿疼痛。查体:T39℃,右脊肋区压痛及叩击痛,尿检:外观混独,RBC8/HP,WBC30/HP,临床诊断为急性肾盂肾炎。]
对该菌所致尿路感染具有有诊断意义的菌落计数为
A.>l0^3CFU/ml
B.>l0^4CFU/ml
C.l0^4-10^5CFU/ml
D.小于l0^5CFU/ml
E.>l0^5CFU/ml
问1:都没有E选项,答案和D选项是一致的
Q
问题编号: 35040
关于补体旁路激活途径的叙述,错误的是
A.激活物质是细胞壁成分
B.从C3激活开始
C.发挥效应比经典途径晚
D.亦有激活效应的扩大
E.旁路途径在感染后期发挥作用
问1:这个C选项是正确的吗?
问2:老师,我知道E是错误的,但是C不应该也是错误的吗?旁路途径在感染早期发挥作用,不应该旁路途径比经典途径早吗?而不是晚。
问3:按照老师这边的解析,这个题目应该选择C,因为C是错误的,E是正确的。
Q
问题编号: 35207
患者女,32岁,因关节疼痛近2年,眼睑浮肿16个月,干咳1个月,神志欠清20天于2015年12月23日收住院,2年前患者诊断为SLE。此次入院实验室检查:HB78g/L,WBC5.2X10^9/L,PLT120X10^9/L。尿常规:蛋白5g/L。血白蛋白18g/L,肝肾功能未见异常。肌酶谱:CK、AST正常。红细胞沉降率98mm/h。补体C3409mg/L,抗核抗体(ANA)(-),抗双链DNA(dsDNA)抗体(+),其他自身抗体检测为(-)。
实验室ANA检测结果为阴性,应考虑是
A.前带现象
B.后带现象
C.等价带
D.前带或者后带
E.前带和后带
问1:这题解释是后带,答案是前带,应该是哪个
Q
问题编号: 41600
抗原与抗体结合的位置称为
A.免疫原
B.表位
C.抗体决定簇
D.吞噬体
E.氨基酸基团
问1:解析
Q
问题编号: 41350
关于标本采集的叙述,错误的是
A.大便检查应选取粘液、血液部分
B.痰液检查应防止唾液混入
C.采集末梢血时应防止组织液混入
D.脑脊液穿刺应防止外伤性血液的渗入
E.输液患者输液完毕至少半小时后,方可采集血液标本
问1:输液完成后,多久可以采集血液标本
Q
问题编号: 46745
患者,女,50岁。尿急、尿频、尿痛,发高烧,腰痛1d到医院就诊。查体:体温39.5℃,血压110/79mmHg,肾肋角及输尿管压痛阳性。实验室检查:血常规WBC13.7×10^9/L,NEU92.9%;留晨尿做尿常规检查:尿干化学检查显示白细胞(+++),红细胞(),亚硝酸盐阳性,尿蛋白();尿沉渣镜检显示白细胞10个/HP,红细胞12个/HP,脓细胞(+)。最可能的临床诊断是
A. 急性肾小球肾炎
B. 肾病综合征
C. 急性间质性肾炎
D. 尿路感染
E. 尿路结石
问1:尿急,尿痛,腰疼,脓细胞,这些不应该是肾病综合症?
Q
问题编号: 28970
如图所示为尿沉渣显微镜检查,图片中显示的细胞是

A.白细胞
B.肾小管上皮细胞
C.移形上皮细胞(底层)
D.移形上皮细胞(中层)
E.移形上皮细胞(表层)
问1:怎么区分鳞状上皮细胞和移行上皮细胞(表、中、底)
Q
问题编号: 40240
STGT试验延长,用硫酸钡吸附血浆不能纠正,用正常血浆及正常血清均能纠正,提示
A.因子Ⅷ缺乏
B.因子Ⅸ缺乏
C.因子Ⅺ缺乏
D.因子Ⅻ缺乏
E.血循环中存在抗凝物质
问1:好难,无从下手!如何分析呀!
Q
问题编号: 34608
关于均相酶免疫测定,以下哪一项是正确的
A.其反应是非竞争性的,多用于大分子物的测定
B.常利用酶标抗原与抗体结合后的空间位阻降低酶活性
C.酶标抗原与待测抗原竞争结合抗体,故反应终信号与待测抗原量呈负相关
D.不须分离结合的与游离标记物,简化操作,提高灵敏度
E.要预先用固相载体吸附抗原或抗体
问1:解释是D,答案是B,是不是应该就是D选项。
Q
问题编号: 41581
SS琼脂平板常用的抑制革兰阳性菌生长的抑制剂是
A.蛋白胨
B.酚红
C.亚硫酸钠
D.胆盐
E.磷酸钠
问1:没有解析
Q
问题编号: 42551
关于尿比密和尿渗量的描述,错误的
A.两者都能反映肾脏的浓缩稀释功能
B.尿比密是尿液中所含容质浓度的指标
C.尿渗量主要与溶质颗粒数量有关
D.尿比密受大分子蛋白质和糖的影响较大
E.尿比密与尿液有机物含量关系不大
问1:有机物含量多少影响尿比密
Q
问题编号: 42547
不符合急性淋巴细胞白血病特点的是
A.血涂片中可见大量幼红细胞
B.血涂片分类可见原始细胞
C.骨髓增生极度或明显活跃
D.血涂片或骨髓涂片中篮细胞(涂抹细胞)多见
E.骨随涂片原始细胞>30%
问1:急淋跟慢淋的区别
Q
问题编号: 42528
下列属于病理性结晶的是
A.尿酸结晶
B.亮氨酸结晶
C.三联磷酸盐结晶
D.草酸钙结晶
E.磷酸钙结晶
问1:尿酸结晶是生理性的吗?
Q
问题编号: 30347
骨髓检查不能确诊的疾病是
A.白血病
B.再生障碍性贫血
C.巨幼细胞贫血
D.溶血性贫血
E.恶性组织细胞病
问1:再障和溶血贫都是支持性检查,那B为什么不选
Q
问题编号: 41798
检测AML-M3微量残留白血病细胞的分子标志是
A.AML1-MTG8(RNA)
B.BCR-ABL(RNA)
C.CBFβ-MYH11(RNA)
D.MLL-AF(RNA)
E.PML-RARA(RNA)
问1:缩写的全称分别是什么?
Q
问题编号: 42280
正常人空腹12小时后,血清中不含有
A. HDL
B. LDL
C. IDL
D. VLDL
E. CM
问1:答案不懂并需要解析